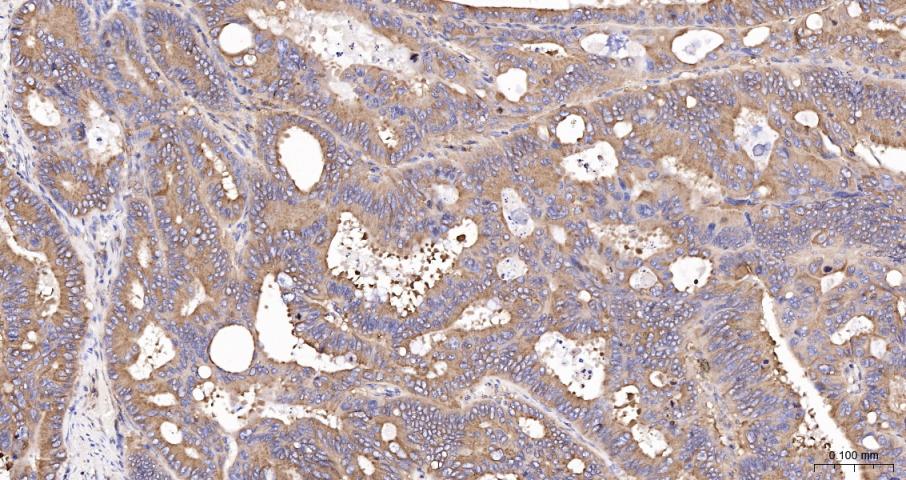
beta I Tubulin Recombinant Rab

相关产品推荐更多 >

phospho-MKK3(Ser218) + MKK6(Ser207) Rabbit pAb, BF555 conjugated(bs-3274R-BF555)-100ul
¥2980
NAT10 Rabbit pAb, HRP conjugated(bs-7757R-HRP)-100ul
¥2980
Cystatin C Mouse mAb, Biotin conjugated(bsm-43167M-Bio)-100ul
¥2980
CLACP Rabbit pAb, PE conjugated(bs-11643R-PE)-100ul
¥2980
MMP10 Rabbit pAb, HRP conjugated(bs-23106R-HRP)-100ul
¥2980
万千商家帮你免费找货
0 人在求购买到急需产品
- 详细信息
- 技术资料
- 应用范围:
产品信息以Bioss网站为准
- 规格:
100ul
| 产品编号 | bsm-33041R-HRP |
| 英文名称 | beta I Tubulin Recombinant Rabbit mAb, HRP conjugated |
| 中文名称 | HRP标记的微管蛋白β1 tubulin(内参)重组兔单抗 |
| 英文别名 | 2810484G07Rik; Beta tubulin 1, class VI; Class VI beta tubulin; dJ543J19.4; M(beta)1; TBB1_HUMAN; TUBB1; Tubulin beta 1 class VI; Tubulin beta-1 chain; Tubulin, beta 1; tubulin, beta1; |
| 产品应用 | IHC-P=1:100-500, WB=1:20000-100000, IHC-F=1:100-500 Not yet tested in other applications. |
| 抗体来源 | Rabbit |
| 免疫原 | KLH conjugated synthetic peptide derived from human beta I Tubulin |
| 亚型 | IgG |
| 纯化方法 | affinity purified by Protein A |
| 克隆类型 | Recombinant |
| 浓度 | 1mg/ml |
| 储存液 | 0.01M TBS (pH7.4) with 1% BSA, 0.02% Proclin300 and 50% Glycerol. |
| 研究领域 | Isotype/Loading Controls > Loading Controls > Beta Tubulin Isotype/Loading Controls > Loading Controls > Tubulin Signal Transduction > Cytoskeleton / ECM > Cytoskeleton > Microtubules > Tubulin Tags & Cell Markers > Subcellular Markers > Cytoskeleton > Microtubules |
| 亚基 | Dimer of alpha and beta chains. A typical microtubule is a hollow water-filled tube with an outer diameter of 25 nm and an inner diameter of 15 nM. Alpha-beta heterodimers associate head-to-tail to form protofilaments running lengthwise along the microtubule wall with the beta-tubulin subunit facing the microtubule plus end conferring a structural polarity. Microtubules usually have 13 protofilaments but different protofilament numbers can be found in some organisms and specialized cells. Interacts with RANBP10. |
| 亚细胞定位 | Cytoplasm, cytoskeleton |
| 组织特异性 | Hematopoietic cell-specific. Major isotype in leukocytes, where it represents 50% of all beta-tubulins. |
| 翻译后修饰 | Some glutamate residues at the C-terminus are polyglutamylated, resulting in polyglutamate chains on the gamma-carboxyl group (PubMed:26875866). Polyglutamylation plays a key role in microtubule severing by spastin (SPAST). SPAST preferentially recognizes and acts on microtubules decorated with short polyglutamate tails: severing activity by SPAST increases as the number of glutamates per tubulin rises from one to eight, but decreases beyond this glutamylation threshold (PubMed:26875866). _x000D_ Some glutamate residues at the C-terminus are monoglycylated but not polyglycylated due to the absence of functional TTLL10 in human. Monoglycylation is mainly limited to tubulin incorporated into axonemes (cilia and flagella). Both polyglutamylation and monoglycylation can coexist on the same protein on adjacent residues, and lowering glycylation levels increases polyglutamylation, and reciprocally. The precise function of monoglycylation is still unclear (Probable). _x000D_ Phosphorylated on Ser-172 by CDK1 during the cell cycle, from metaphase to telophase, but not in interphase. This phosphorylation inhibits tubulin incorporation into microtubules. |
| 相似性 | Belongs to the tubulin family. |
| 功能 | Tubulin is the major constituent of microtubules. It binds two moles of GTP, one at an exchangeable site on the beta chain and one at a non-exchangeable site on the alpha chain (By similarity). |
| 保存条件 | Shipped at 4℃. Store at -20℃ for one year. Avoid repeated freeze/thaw cycles. |
| 背景资料 | This gene encodes a member of the beta tubulin protein family. Beta tubulins are one of two core protein families (alpha and beta tubulins) that heterodimerize and assemble to form microtubules. This protein is specifically expressed in platelets and megakaryocytes and may be involved in proplatelet production and platelet release. A mutations in this gene is associated with autosomal dominant macrothrombocytopenia. Two pseudogenes of this gene are found on chromosome Y.[provided by RefSeq, Jul 2010] |
| 应用 | 推荐稀释比例 |
| {IHC-P} | {1:100-500} |
| {WB} | {1:20000-100000} |
| {IHC-F} | {1:100-500} |

Paraformaldehyde-fixed, paraffin embedded Rat Cerebrum; Antigen retrieval by boiling in sodium citrate buffer (pH6.0) for 15 min; The section was incubated with beta I Tubulin Monoclonal Antibody (bsm-33041R-HRP) at 1:200 overnight at 4°C, and DAB (C-0010) staining.

Paraformaldehyde-fixed, paraffin embedded Human Cerebrum; Antigen retrieval by boiling in sodium citrate buffer (pH6.0) for 15 min; The section was incubated with beta I Tubulin Monoclonal Antibody (bsm-33041R-HRP) at 1:200 overnight at 4°C, and DAB (C-0010) staining.

Paraformaldehyde-fixed, paraffin embedded Rat Spleen; Antigen retrieval by boiling in sodium citrate buffer (pH6.0) for 15 min; The section was incubated with beta I Tubulin Monoclonal Antibody (bsm-33041R-HRP) at 1:200 overnight at 4°C, and DAB (C-0010) staining.

Paraformaldehyde-fixed, paraffin embedded Mouse Spleen; Antigen retrieval by boiling in sodium citrate buffer (pH6.0) for 15 min; The section was incubated with beta I Tubulin Monoclonal Antibody (bsm-33041R-HRP) at 1:200 overnight at 4°C, and DAB (C-0010) staining.

Paraformaldehyde-fixed, paraffin embedded Rat Cerebellum; Antigen retrieval by boiling in sodium citrate buffer (pH6.0) for 15 min; The section was incubated with beta I Tubulin Monoclonal Antibody (bsm-33041R-HRP) at 1:200 overnight at 4°C, and DAB (C-0010) staining.

Paraformaldehyde-fixed, paraffin embedded Mouse Cerebellum; Antigen retrieval by boiling in sodium citrate buffer (pH6.0) for 15 min; The section was incubated with beta I Tubulin Monoclonal Antibody (bsm-33041R-HRP) at 1:200 overnight at 4°C, and DAB (C-0010) staining.

Paraformaldehyde-fixed, paraffin embedded Mouse Cerebrum; Antigen retrieval by boiling in sodium citrate buffer (pH6.0) for 15 min; The section was incubated with beta I Tubulin Monoclonal Antibody (bsm-33041R-HRP) at 1:200 overnight at 4°C, and DAB (C-0010) staining.
Paraformaldehyde-fixed, paraffin embedded Human Colon Cancer; Antigen retrieval by boiling in sodium citrate buffer (pH6.0) for 15 min; The section was incubated with beta I Tubulin Monoclonal Antibody (bsm-33041R-HRP) at 1:200 overnight at 4°C, and DAB (C-0010) staining.

Paraformaldehyde-fixed, paraffin embedded Human Breast Cancer; Antigen retrieval by boiling in sodium citrate buffer (pH6.0) for 15 min; The section was incubated with beta I Tubulin Monoclonal Antibody (bsm-33041R-HRP) at 1:200 overnight at 4°C, and DAB (C-0010) staining.

25 ug total protein per lane of various lysates (see on figure) probed with beta I Tubulin monoclonal antibody, conjugated (bsm-33041R-HRP) at 1:50000 dilution and 4°C overnight incubation.
风险提示:丁香通仅作为第三方平台,为商家信息发布提供平台空间。用户咨询产品时请注意保护个人信息及财产安全,合理判断,谨慎选购商品,商家和用户对交易行为负责。对于医疗器械类产品,请先查证核实企业经营资质和医疗器械产品注册证情况。
 技术资料
技术资料暂无技术资料 索取技术资料
beta I Tubulin Recombinant Rabbit mAb, HRP conjugated(bsm-33041R-HRP)-100ul
¥3200





